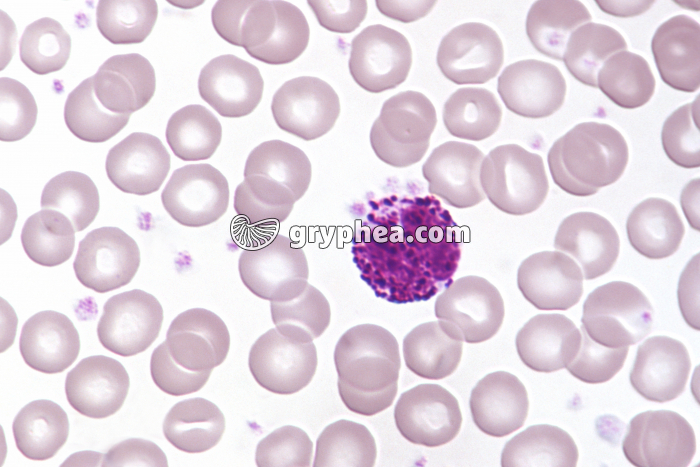
Granulocyte Basophile x400 - gryphea.com

1 crédit = 6.00€ TTC
(Hors pack)
si vous êtes enseignant, le site gryphea.org a été conçu spécialement pour vous !
Catégorie de globules blancs au noyau lobé et au cytoplasme plus ou moins granuleux, chargés de l’immunité non spécifique à court terme ou immédiate. On des qualifie aussi de «polynucléaires». Ils sont répartis en plusieurs catégories : granulocytes neutrophiles, éosinophiles ou basophiles selon l’affinité de leur cytoplasme à des colorants neutres, acides ou basiques. Les granulocytes neutrophiles sont des cellules phagocytaires (ou phagocytes), qui ingèrent les éléments étrangers comme les bactéries. Les granulocytes éosinophiles s’attaquent aux parasites en libérant le contenu de leurs granules riches en enzymes à l’intérieur des parasites sanguins. Les granulocytes basophiles accélèrent la réaction inflammatoire en déversant de l’histamine dans le milieu intérieur, ce qui attire les autres leucocytes.
La suite du commentaire est réservée aux inscrits, créez un compte gratuitement.